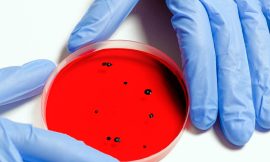
O congelamento mata bactérias?

Quando se trata de seios, a maioria das pessoas pensam apenas em vaidade, mas existem problemas e perigos eminentes relacionados.
Nesta publicação você descobrirá sobre mastopexia, o que é e como ela pode influenciar no dia a dia da mulher, bem como em sua saúde.
O que é a mastopexia?
É a condição médica onde uma pessoa tem cicatrizes em seus seios depois de dar à luz, medicamente denominada como ginecomastia. Este fenômeno é uma realidade desajeitada para a maioria das mulheres que sofreram esse tipo de mudança física.
Por causa disso, as mulheres que tiveram essa experiência queriam estar cientes dos melhores tratamentos para se recuperar desta chamada condição e, eventualmente, ganhar de volta a confiança que se vai embora com um peito flácido ou liso.
Mastopexia e suas formas

Existem três formas conhecidas de mastopexia ou ginecomastia que incluem: balólico (ou mastopexia de balão), ginecomastia com um implante hidráulico, e a forma mais grave dessa mudança física, a verdadeira ginecomastia.
Todos estes tipos de variações são tratados de maneira diferente, dependendo de quão grave é o caso. Para os homens que têm mastopexia, procedimentos cirúrgicos podem ser feitos para remover o excesso de tecido. Além disso, também há tratamentos disponíveis para homens que têm um implante hidráulico para a remoção das deformidades provocadas por esta condição.
O processo de recuperação para cada tipo de mastopexia difere. Para pacientes que têm um implante hidráulico, a principal preocupação é as cicatrizes flácidas ou glandulares que podem ser escondidas após a cirurgia.
Quanto ao último, a recuperação geralmente depende de quão severa a flacidez do tecido será. O regime de exercício físico deve ser seguido e a perda de peso gradual e ganho de massa magra devem ser observados. Os homens que têm a forma de balão dessa doença devem ter um exame físico cuidadoso antes de passar por um procedimento cirúrgico.
A flacidez e suas relações com o peso
O principal problema com esta condição é o excesso de peso que é adquirido durante os anos da vida adulta. Isso é causado pelo aumento dos fluidos corporais, especialmente a urina – e também por conta da retenção hídrica.
Esses fluidos combinados com as mudanças hormonais e associados ao ciclo menstrual resultam no desenvolvimento da pele flácida nas mulheres. Essas marcas são chamadas de medula em terminologia médica.
O que é a ptose mamária?
A ptose mamária é uma deformidade absoluta que impede o crescimento dos seios. Tais deformações são perceptíveis nos topos dos seios. Os mamilos e as aréolas também são distorcidos. Em alguns casos, o mamilo e a aréola de apenas um seio são afetados.
Cirurgia de elevação do peito
Uma cirurgia de elevação de mama é feita para reduzir a excessiva flacidez ou formação marrom sob os seios. Durante o procedimento de mastopexia, os tecidos excedentes ou o tecido adiposo são removidos para dar equilíbrio.
Após o procedimento, o excesso de pele e gordura são reabsorvidos no corpo através da incisão feita.
Dobra inframamária
Uma dobra inframamária ocorre quando há uma superprodução anormal dos músculos peitorais. Isso ocorre porque os músculos peitorais não estão posicionados na posição adequada causando fold infra-mamários. Essas dobras ocorrem no seio (Aréola e o mamilo).
O que é a mastopexia para os homens?
A mastopexia para homens é feita quando há gordura excessiva e a pele se acumula na área do peito. Geralmente envolve a remoção de gordura e pele por meio de uma incisão na axila. Para este procedimento, é necessária anestesia geral.
Já as mulheres que sofrem de casos extremos de flacidez passarão por um procedimento específico para corrigir seu problema. Este procedimento é ideal para mulheres que desejam recuperar sua forma jovem e se sentir sexy novamente. Para este procedimento, é necessária anestesia geral.
É importante salientar que este tipo de processo cirúrgico deve ser feito em pessoas que gozam de sua plena saúde mental e física. Pessoas que sofrem de problemas sério como a síndrome de west expectativa de vida reduzida não devem passar por este tipo de procedimento, por exemplo.
Homens que têm um grande peito e perderam parte do seu peso corporal devido ao fumo excessivo, diabetes ou falta de exercício podem se beneficiar deste procedimento. Isto é ideal para homens que perderam sua capacidade de controlar sua ereção (disfunção erétil) também.
Uma pequena cicatriz é normalmente presente na área do abdômen após este procedimento, que se tornará menor com o tempo.
Se você tem uma mama anormalmente grande que gostaria de recuperar, mas não quer se submeter aos métodos tradicionais de diminuição da mama através da cirurgia, então este procedimento pode ser para você.
Durante esta operação, seu médico removerá o excesso de gordura do seu corpo, bem como qualquer pele ou tecido que possa estar presente.
Se você tiver alcançado ou estiver perto de seus trinta anos e está infeliz com o tamanho de seus seios por razões estéticas (apenas), este procedimento pode ser para você também. Durante este procedimento, o excesso de gordura é removido do seu corpo, bem como qualquer excesso de pele ou tecido que incomode sua aparência.
Seu cirurgião criará uma pequena incisão onde o excesso de tecido estava localizado e removerá ele de forma suave para fora dos músculos do peito, dando-lhe uma aparência menor, que seja esteticamente agradável e confortável.